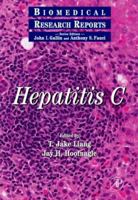
Hepatitis C (A Volume in the Biomedical Research Reports) (Biomedical Research Reports)

Explore More
Explore More
Top Picks
Bestsellers
Hematology
Clinical
Internal Medicine
Medical
Medical Books
Medicine
Commonalities among these books on Hematology include: - They are all comprehensive guides that cover various aspects of hematology, from laboratory testing and diagnosis to blood banking and transfusion practices. - They are intended for medical professionals, nurses, dialysis personnel, and patients alike. - They provide in-depth examination of the principles and applications of hematology, phlebotomy techniques and procedures, and the intertwined histories of medicine and commerce.